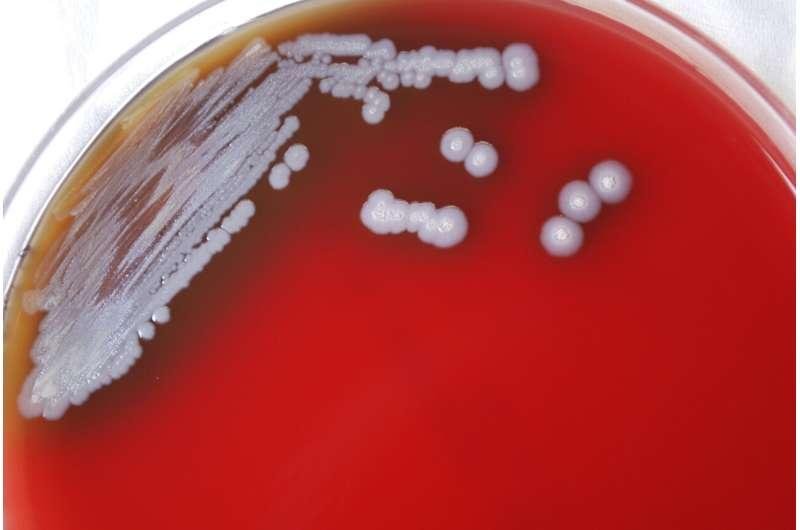
undefined

本周三,美国疾病控制与预防中心CDC发文:在美国的土壤和水样中首次发现了一种罕见细菌,可导致高达50%的感染者死亡!

据悉,这种罕见细菌名叫Burkholderia pseudomallei,是一种类鼻疽伯克霍尔德菌,会使感染的人患上类鼻疽病,主要分布于热带以及亚热带地区,包括南亚、东南亚、澳大利亚北部以及中南美洲的波多黎各等地。
在美国,差不多每年会有10来个人会因为感染类鼻疽杆菌而患上类鼻疽病,但这些病例基本上都有与国际旅行和一些受污染的进口产品有关。该细菌曾被认为“不会在美国本土发现”。

然而,在2020年和2022年,两个毫无关联且都住在美国南部密西西比州墨西哥湾沿岸地区的人都患上了类鼻疽病后,立即引起了CDC重视,并派工作人员前往这两名患者的家中调查。
果然!通过对这两名患者家附近的土壤和水收集的样本来看,有3个地方的样本呈现出类鼻疽杆菌阳性!
CDC的专家表示,目前尚不清楚这种细菌在该地区出现了多久,也不知道其他的州是否也有出现,但至少肯定的是,从2020年起,类鼻疽杆菌就已经出现在了墨西哥湾沿岸地区。
更糟糕的是,墨西哥湾沿岸的环境条件也有利于类鼻疽杆菌的生长......
CDC表示,类鼻疽病例的治疗与医疗水平有关,在一些非发达国家,它的死亡率高达50%,而在发达国家,它的死亡风险可以降到10%左右。
但由于病患会出现多种非特异性症状,且发作时间可能在24小时至4周内不等,因此它的确诊比较困难,很容易被医务人员判断为肺结核、肺炎或其他肺部问题。
所以,居住在密西西比州墨西哥湾沿岸的童鞋,一定要采取措施保护好自己啊!

类鼻疽病的表现症状:
发烧、关节痛、头痛、全身不适、咳嗽、胸痛、呼吸急促等
类鼻疽病传播途径:
接触含菌的水、土壤、污染物(人际传播也有可能,但极其罕见)
如何预防类鼻疽病:
- 疫区(密西西比州墨西哥沿岸)需尽量避免接触土壤和泥水,尤其是大雨后,需要保护身上的开放性伤口。
- 园艺、庭院工作或农业工作时,尤其是洪水和暴风雨后,需穿上防水靴避免脚或腿部感染。
- 直接接触土壤时,需带上手套保护双手。
本文由北美省钱快报小编Joyce整理,图片及信息来自CDC、DailyMail等,版权属于原作者。本文不代表本公众号立场,未经许可不得擅自转载,否则将追究责任。(来源:CNN,封面图Credit:CBS)







































最新评论 10
: 墨西哥湾😱刚打算周末去休斯顿海边玩玩😭 墨西哥湾😱刚打算周末去休斯顿海边玩玩😭
: 真是无语,一波一波 真是无语,一波一波
: 没完没了 没完没了
: 很多病毒一直都有,现在网络发达了,感觉就是吓唬老百姓,也许是又要推出新疫苗了吧😁底层的人民不会被关注的,该怎么活就怎么活吧,珍惜身边的一切吧,你永远也不知道幸运和不幸哪个先到来。 很多病毒一直都有,现在网络发达了,感觉就是吓唬老百姓,也许是又要推出新疫苗了吧😁底层的人民不会被关注的,该怎么活就怎么活吧,珍惜身边的一切吧,你永远也不知道幸运和不幸哪个先到来。
: 一天天的各种病![[恐怖]](/assets/emoji/comment-emoji/dm_kongbu@2x.png?v=1)
![[恐怖]](/assets/emoji/comment-emoji/dm_kongbu@2x.png?v=1)
![[恐怖]](/assets/emoji/comment-emoji/dm_kongbu@2x.png?v=1) 一天天的各种病
一天天的各种病![[恐怖]](/assets/emoji/comment-emoji/dm_kongbu@2x.png?v=1)
![[恐怖]](/assets/emoji/comment-emoji/dm_kongbu@2x.png?v=1)
![[恐怖]](/assets/emoji/comment-emoji/dm_kongbu@2x.png?v=1)
: 打开新闻一看全是好消息…. not 打开新闻一看全是好消息…. not
: 症状怎么跟covid很像啊 症状怎么跟covid很像啊
: 这封面图看了心里不舒服![[恐怖]](/assets/emoji/comment-emoji/dm_kongbu@2x.png?v=1) 这封面图看了心里不舒服
这封面图看了心里不舒服![[恐怖]](/assets/emoji/comment-emoji/dm_kongbu@2x.png?v=1)
: 看到这个的时候,正徒手搞花花草草的土…土…土… 虽然明白文中说的是当地疫区或者洪水过后的户外庭院,但是就是会联想到,会害怕呀![[二哈]](/assets/emoji/comment-emoji/dm_erha@2x.png?v=1) 看到这个的时候,正徒手搞花花草草的土…土…土… 虽然明白文中说的是当地疫区或者洪水过后的户外庭院,但是就是会联想到,会害怕呀
看到这个的时候,正徒手搞花花草草的土…土…土… 虽然明白文中说的是当地疫区或者洪水过后的户外庭院,但是就是会联想到,会害怕呀![[二哈]](/assets/emoji/comment-emoji/dm_erha@2x.png?v=1)
: 这个世界怎么了? 这个世界怎么了?